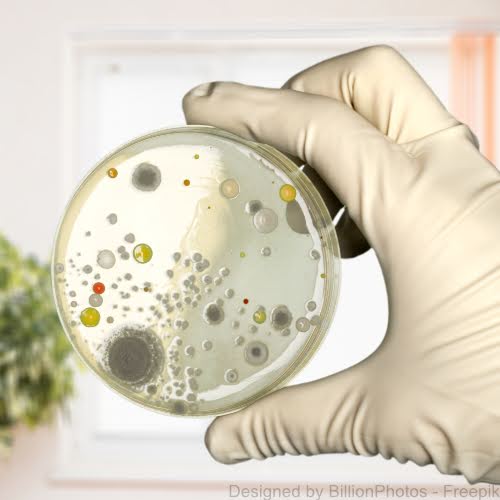
Enterokokken in Petrischale Eine Hand mit weißen Handschuhen hält eine Petrischale in die Kamera, auf der sich Kolonien von Enterokokken (enterococcus faecalis) gebildet haben.

In diesem Artikel erfahren Sie
✅ was Enterokokken sind
✅ die Gefahr von Antibiotika-resistenten Enterokokken
✅ die Gefahr von Enterokokken im Trinkwasser und in Lebensmitteln
✅ welche Symptome und Krankheiten bei einer Infektion auftreten können
✅ warum Sie aus Brunnen gewonnenes Trinkwasser unbedingt auf Enterokokken testen lassen sollten
Enterokokken – Symptome, Infektion, Gefahren und Behandlung
Inhalt

Was sind Enterokokken?
Enterokokken sind sogenannte Milchsäurebakterien und kommen sowohl in Menschen, Tieren als auch in verschiedenen Lebensmitteln vor. Im Darm jedes Menschen existieren viele verschiedene Varianten dieser Bakterien. Enterokokken kommen auch in der unbelebten Umwelt vor, da sie außerhalb des Körpers bis zu einer Woche überleben können. Gelangen Enterokokken in andere Körperregionen, können sie verschiedene Arten von Infektionen verursachen (Wundinfektionen, Harnwegsinfektionen, Blutvergiftungen, etc.).
👉 Mehr dazu: Landeszentrum für Gesundheit Nordrhein-Westfalen, 2017 Vancomycin-resistente Enterokokken.

Wie infiziert man sich mit Enterokokken?
Die Infektion durch Enterokokken erfolgt entweder durch Bakterien aus dem eigenen Körper oder durch Bakterien aus der Umwelt.
Eine sehr häufige Erkrankung, die vor allem durch E.coli und Enterokokken des eigenen Darms ausgelöst wird, ist die Harnwegsinfektion, von welcher etwa 50 % - 70 % aller Frauen einmal in ihrem Leben betroffen sind.1
Eine Übertragung von Enterokokken durch die Umwelt erfolgt dagegen, wenn zum Beispiel Enterokokken aus dem Darm eines anderen Menschen durch einen Handkontakt übertragen werden. Das anschließende Kratzen einer Wunde kann dann letztlich zu einer Wundinfektion führen. Der Kontakt mit kontaminierten Oberflächen wie einer Türklinke reicht jedoch bereits aus, da Enterokokken auch mehrere Tage außerhalb des Körpers überleben können.2

Antibiotika resistente Enterokokken
Besonders gefährlich können Enterokokken bei stationären oder ambulanten medizinischen Maßnahmen sein. Nach dem Robert Koch Institut nehmen Enterokokken in Krankenhäusern zu und führen dadurch zu mehr tödlichen Infektionen.1
Einige Enterokokken-Stämme können resistent gegen verschiedene Antibiotika sein, was eine erfolgreiche medizinische Behandlung erschwert. Vancomycin-resistente Enterokokken haben zum Beispiel eine Resistenz gegenüber Vancomycin sowie gegenüber weiterer Antibiotika.2
Neben Vancomycin können Enterokokken auch Resistenzen gegen die folgenden Antibiotika ausbilden3:
- Mezlocillin
- Piperacillin
- Ampicillin
- Tetrazykline
- Gyrasehemmer

Enterokokken in Lebensmitteln
Enterokokken kommen in vielen Lebensmitteln vor und werden unter anderem bei der Herstellung verschiedener Käsesorten eingesetzt. Die meisten Stämme von Enterokokken sind für den Menschen ungefährlich – in der Medizin werden bestimmte Stämme von Enterokokken sogar in Probiotika eingesetzt, um die Darmflora positiv zu beeinflussen.
Insbesondere manche E. faecalis-Stämme können bei Menschen mit stark geschwächten Immunsystemen Infektionen auslösen. Das Bundesinstitut für Risikobewertung (BfR) weist jedoch darauf hin, dass trotz einer Zunahme der Infektionen, diese bisher ausschließlich in Krankenhäusern stattgefunden haben. Einen Zusammenhang zwischen dem Verzehr von Lebensmitteln und diesen in Krankenhäusern auftretenden Infektionen hält das BfR für unwahrscheinlich.
Quelle und weitere Informationen

Erkrankungen und Symptome durch Enterococcus faecalis, Enterococcus faecium und andere Enterokokken-Unterarten
Enterokokken können die verschiedensten Symptome und Erkrankungen auslösen. Beim Menschen werden diese am häufigsten durch die „Unterarten“ Enterococcus faecalis und Enterococcus faecium hervorgerufen. Nach dem medizinischen Nachschlagewerk MSD Manual können Enterokokken die folgenden gesundheitlichen Beschwerden auslösen. Klicken Sie auf die Links, um Näheres zu den jeweiligen Symptomen zu erfahren:
- Harnwegsinfektionen (ein häufiges Enterokokken-Symptom bei Frauen)
- Bakterien im Blut
- Infektion der Herzklappen
- Infektionen der Haut und des Unterhautgewebes
- Infektion der Prostata
- Wundinfektionen
- Abszesse im Abdomen
Quelle und weitere Informationen
Tipp: Enterokokken können unter anderem durch eine Urinuntersuchung im Labor nachgewiesen werden. Unser Ratgeber „Enterokokken im Urin: Ursachen & Erkrankungen, geeignete Nachweismethoden, Behandlungsmöglichkeiten“ enthält zu diesem Themenbereich viele weitere Informationen.

Welche Möglichkeiten zur Behandlung gibt es?
Eine Infektion mit Enterokokken wird mit Antibiotika behandelt. Handelt es sich um Vancomycin-resistente-Enterokokken, müssen Reserve-Antibiotika eingesetzt werden, denen gegenüber die Bakterien noch keine Resistenz entwickelt haben. Dadurch verzögert sich die Behandlung von Patienten und das Risiko von ernsthaften Komplikationen steigt. Ob man Infektionen mit zum Beispiel Enterococcus faecalis ohne Antibiotika behandeln kann, sollte immer ein Arzt entscheiden. Verschleppte oder nicht behandelte Infektionen können mitunter schwere Folgeerkrankungen hervorrufen.
Quelle und weitere Informationen
Bundesgesundheitsministerium, 2023 - Die wichtigsten Begriffe zum Thema Antibiotika-Resistenzen

Enterokokken im Trinkwasser
Aufgrund der großen Anzahl verschiedener Typen von Bakterien, die sich im Wasser befinden können, werden bei der Testung der Wasserqualität in der Regel sogenannte Indikatorkeime eingesetzt. Das Auftreten dieser Indikatorkeime geht in der Regel mit einer erhöhten Anzahl anderer Bakterien einher, die bei Menschen zu Krankheiten führen können.
Geeignete Indikatorkeime sind nach dem Landesamt für Gesundheit und Soziales Mecklenburg Vorpommern1:
- E. coli
- Coliforme Bakterien
- Intestinale Enterokokken
Falls Sie Ihr Trinkwasser aus einem Brunnen beziehen, sollten Sie unbedingt mindestens einmal jährlich die Wasserqualität testen lassen. Nach der EU-Richtlinie 2020/2184 dürfen in 100 Milliliter Wasser keine Enterokokken nachweisbar sein, wenn das entsprechende Wasser für den menschlichen Gebrauch verwendet wird.2
Die Überprüfung von Enterokokken im Trinkwasser wird in Deutschland von den Wasserversorgern durchgeführt. Wird das Wasser jedoch aus einem Brunnen bezogen, ist der Betreiber dafür verantwortlich, die Wasserqualität zu überprüfen.
👉 Hier erfahren Sie mehr zu den Grenzwerten im Trinkwasser nach der deutschen Trinkwasserverordnung.
Quellen und rechtliche Grundlage

Schon gewusst?
Enterokokken sind in der Regel nur gelegentlich und in geringen Konzentrationen in der gesunden Mundflora nachweisbar. Die Bakterien kommen jedoch weit häufiger in zum Beispiel tiefen Zahnfleischtaschen, bei fortgeschrittener Parodontitis und paradontalen Abszessen vor. Oft werden Enterokokken bei Infektionen von gefüllten Wurzelkanälen nachgewiesen. Enterococcus faecalis gilt sogar als der Hauptverursacher beim Scheitern von endodontischen Eingriffen (Behandlung des Zahninneren wie Wurzelkanalbehandlungen). Dies resultiert unter anderem daraus, dass Enterokokken sehr gut Biofilme bilden können. Diese schützen die Bakterien in hohem Maße vor bakteriziden Substanzen wie Antibiotika.1
1Vgl.: Die Zahnarztwoche (dzw): Enterokokken: Opportunist in oralen Biofilmen. 2022.

Testen Sie jetzt Ihr Wasser auf Enterokokken!
Mit unseren Test-Kits Brunnenwassertest Hygiene und Brunnenwassertest Komplett können Sie Ihr Brunnenwasser auf Enterokokken und viele weitere potenzielle Schadstoffe untersuchen lassen. Dabei können Sie die Probe einfach selbst entnehmen und von unserem Fachlabor analysieren lassen. Sie erhalten in kurzer Zeit einen ausführlichen Ergebnisbericht, den Sie bequem von zu Hause aus auf unserem Kundenportal abrufen können:

✔️ Speziell für Brunnen & Quellen
✔️ Mikrobiologische Kontrolle
✔️ inkl. E. coli, Enterokokken

✔️ Speziell für Brunnen & Quellen
✔️ 2 in 1: Chemie & Mikrobiologie
✔️ Umfassendste Brunnenanalyse
👉 Hier finden Sie weitere Informationen zu Enterokokken im Trinkwasser.
👉 Hier finden Sie alle unsere Wassertests
Haftungsausschluss: Trotz sorgfältiger Zusammenstellung der Inhalte können wir die Aktualität, Korrektheit und Vollständigkeit der Informationen nicht garantieren. Wenden Sie sich bei gesundheitlichen Fragen an einen Arzt oder Apotheker!